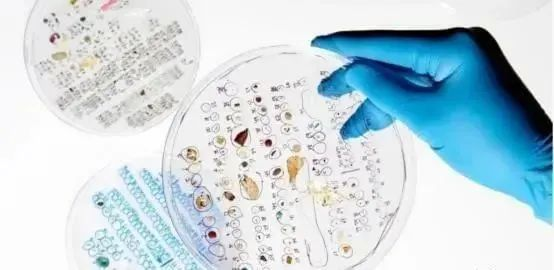

Heat it in 3 minutes to release hundreds of billions of plastic particles! Try to use less disposable plastic cups
Heat it in 3 minutes to release hundreds of billions of plastic particles! Try to use less disposable plastic cupsPackaging tribe 2018 2023-08-23 00:00, published in Guangdong
Editor's note: Disposable plastic cups, hot coffee, hot soybean milk, and coated disposable paper cups are products that are used almost every day in our daily life. Microwaves are also available in almost every family. We use it to heat rice, hot vegetables, etc., very convenient, after reading this article, I believe you will not use plastic plates, plastic bowls into the microwave oven heating, will also be as little as possible with disposable plastic cups, coated disposable paper cups and hot drinks.

Heat up for 3 minutes,
It releases billions of microplastic particles per square centimeter
In July 2023, the journal Environmental Science and Technology published a study on the release of microplastics and nanoplastics from plastic containers in different use scenarios. The results found that microwave heating resulted in the highest number of microplastics and nanoplastics released into food, with more than 2 billion nanoplastics and 4 million released per square centimeter of microplastics from containers than those refrigerated or used at room temperature.
Researchers selected composed of polypropylene and polyethylene "food grade plastic container", placed in the microwave after 3 minutes, after analyzing the liquid in the container found a lot of microplastics (about 1 micron in diameter) and smaller nanoscale plastic particles, it is estimated that in 1 square centimeter plastic will release 4.22 million microns plastic particles and 2.11 billion nano plastic particles. For ordinary 90 cups, about 400 square centimeters, each glass releases 1.688 billion micrometer plastic particles and 844 billion nanoplastic particles.
The researchers also found that plastic containers used to heat liquids, including water, milk, produced the highest number of micron plastic particles, or much less micrometer plastic for refrigerated storage of food or drink.
So, if you use the microwave oven to heat food, it is best not to use plastic containers.

What harm do microplastics have to the human body
Professor Yang Xiubin and Hua Kun from Beijing Anzhen Hospital affiliated to Capital Medical University published a paper titled "Detection of Various Microplastics in Heart Surgery Patients" in the journal Environmental Science and Technology. The team concluded that the presence of microplastics detected in body organs is worrying, which are associated with cancer, heart disease, dementia, and fertility problems that could affect the ability of red blood cells to transport oxygen. Now, more research is needed to fully understand the impact of microplastics on the cardiovascular system in humans as well as on outcomes after cardiac surgery.
(Inflammatory reaction caused by plastic)
In 2017, the American Endocrine Association (Endocrine Society) and the International Network for the Elimination of Persistent Organic Pollutants (IPEN) published a report titled "Plastics, Endocrine distractors and Health" (PLASTICS, EDCs & HEALTH), summarizing seven types of endocrine disruptors common in plastic products, as well as their health hazards.
In the production process of plastic, many endocrine disturbances (EDCs, a class of chemicals that interfere with endocrine system and organs, such as bisphenol, alkylphenols, etc.) are often used as additives to have some characteristics, such as color or flexibility. In addition, in the process of plastic production or recycling, they may also be contaminated by endocrine disturbances, such as styrene, dioxin, etc.
Plastic contains endocrine disruptors, can infiltrate food, water and environment, and through food, breathing, skin contact into the human body, harm to the endocrine system and organs, affect the kidney, liver and thyroid function, increase cancer, diabetes, metabolic disorders, nervous system diseases and inflammation risk, may even lead to male and female reproductive development change, infertility and germ cells.

▲ Main endocrine-related organs of the human body, male (left) and female (right). The top to bottom are: pineal gland, hypothalamus, pituitary gland, thyroid gland, parathyroid gland, cardiovascular gland, breast, liver, adrenal gland, kidney, pancreas, adipose tissue, ovary, prostate gland, testis and bone (Photo source: Reference [1])
Reduce microplastics, and do fewer things in life
As us personally, reduce the risk of microplastics entering the body, do these things in life!
1. Try to microwave the plastic utensils as little as possible
Despite many so-called "food grade" plastic utensils, plastic particles are still released in the microwave oven. If you have to use it, use plastic correctly. Do not heat your food or drink in a plastic container or in the dishwasher. In order to reduce the plastic particles released by milk bottles, it is recommended to use glass containers to prepare baby milk powder, wait for the milk to cool before filling the plastic bottle, rinse the bottle with boiled cold water in the non-plastic kettle, so as to wash away the plastic particles released during the disinfection process.
2. Use less plastic for food
The study also pointed out that plastic particles are much less released in food or refrigerated food, but there are still releases.
3. Use less disposable plastic cups and straws as far as possible
Use less disposable plastic cups, plastic water cups, and plastic straws to reduce the risk of microplastics entering the body. If possible, replace plastic with glass or stainless steel (note that paper boxes such as pizza boxes, aluminum cans, etc., may still have bisphenol A).


Gallery copyright pictures, reprint and use may cause copyright disputes
4. Use disposable plastic tableware and packing boxes, possible. Try to eat out or order takeout.
5. Regular vacuuming (rather than cleaning) can reduce the level of plastic particles indoors
In order to reduce the plastic particles in the home dust, it is recommended that regular cleaning (not cleaning) can reduce the indoor plastic particles level, conditional families can buy electronic vacuum cleaner for cleaning; natural clothes, carpet and furniture (cotton, hemp, silk, wool, etc.), rather than synthetic fiber, which can reduce the loss of indoor microplastics.
6. Try not to throw away the used plastic products
Plastic bottles, plastic bags, don't throw around, garbage classification into the designated trash can, reduce the pollution to the environment, avoid microplastics through the food chain into the human body.
Proof of plastic alternatives
, Zam 12
A cup of hot milk tea, hundreds of billions of microplastic
A new study by Christopher Zangmeister, a team of chemists from the National Institute of Standards and Technology (NIST), explores the source and release of microplastics from food-grade nylon bags and low-density polyethylene (LDPE) components. In fact, plastic products based on these two ingredients are common in everyday life, such as baking liners and lined plastic film for disposable coffee cups. The results showed that after placing a 100℃ glass of water in a regular coffee cup for 20min, the researchers detected trillions of plastic nanoparticles per liter of water. In other words, when you enjoy a 500-ml cup of hot coffee or hot milk tea, 500 billion plastic nanoparticles will come into your body!
DOI: 10.1021/acs.est.1c06768
Not only that, but microplastics are already in their infancy. Study Microplastic release from the degradation of polypropylene feeding bottles during infant formula preparation, published in Nature Food, estimates that infants may consume as many as 16 million microplastic particles per liter of infant formula prepared using polypropylene plastic bottles. In the study, the polypropylene baby bottles were sterilized, air-dried, and then poured into water heated to 70℃, according to the WHO standards for the preparation of infant formula. After shaking the bottle for a minute, they filtered the liquid and analyzed it under a microscope, and found millions of microplastic particles. Boling was detected in just one minute, confirming the immediacy of microplastic production. In addition, the researchers found that the water temperature used in the milk powder greatly affected the amount of contaminated particles released. When the water temperature rises from 25℃ to 95℃, the released microplastic particles per liter increased from 600000 to 55 million. That is, the higher the water temperature, the more it will be released.
https://doi.org/10.1038/s43016-020-00171-y
As people keep eating takeout, coffee, and tons of bottled drinks, microplastics are naturally constantly fed into the body. In Canada's Kieran D. Professor Cox and his team on the basis of American diet, according to the food consumption types and different kinds of food contains micro plastic quantity, estimate each person will eat 50000 micro plastic particles per year, if the floating in the air, by breathing inhaled micro plastic, so each year eat the number of micro plastic particles between 74000-121000. By weight, each person eats about 5g of microplastics per week, equivalent to the weight of a bank card. It's never too old to eat plastic. At 5g of plastic particles per week, people are expected to eat a Lego toy in their lifetime, with a little stimulus (bushi).
The researchers found that a single plastic film with an ordinary outer coffee cup, with the heat of hot water, released hundreds of billions of nano-plastic particles into our bodies.

The study comes from a new study conducted last year by chemist Christopher Zangmeister of the National Institute of Standards and Technology (NIST). The researchers used food-grade nylon bags and low-density polyethylene products as samples to explore the source and release of the microplastics. The common disposable outer coffee cup lined with plastic film contains these two main ingredients.
The results showed that after placing a 100℃ cup of hot water in a regular take-out coffee cup, the researchers detected trillions of plastic nanoparticles per liter of water. In other words, when you drink a 500ml cup of hot coffee or hot milk tea, 500 billion plastic nanoparticles will come into your body ~

DOI: 10.1021/acs.est.1c06768
So-called microplastics (Microplastic) refer to plastic fragments and particles less than 5 mm in diameter, released during the use of plastic products, especially for food use. Nanoplastics (Nanoplastics) are the smallest known microplastics, measuring less than 1 μ m and small enough to cross cell membranes. Micro-plastic particles are widely found in our food, water and even the air.

In our daily life, bottled drinks, takeaway boxes, coffee cups... plastic everywhere, it's easy to ignore. As people constantly eat takeout and drink hot coffee, microplastics accumulate into us like a frog boiled in warm water.
In addition, microplastics in infancy. Research published in Nature Food estimates that as many as 16 million microplastic particles per liter of milk powder in polypropylene bottles, which can be detected in just one minute, confirming the immediacy of microplastics. In addition, the researchers found that when the water temperature rose from 25℃ to 95℃, the release of microplastic particles per liter increased from 600,000 to 55 million. In other words, the higher the water temperature, the more microplastics will be released.

https://doi.org/10.1038/s43016-020-00171-y
On the other side, the Canadian Kieran D. Professor Cox and his team based on American eating habits and estimated that they would eat 50,000 microplastic particles per person per year, based on the type of food consumed and the amount of microplastics contained in different types of food. If you include microplastics floating in the air, the number of microplastic particles is 74,000 to 121,000 per person per year. Eat about 5 grams of microplastic per person per week, equivalent to the weight of a bank card.
And these microplastics that enter the body can eventually lead to various health problems, such as inflammation, cardiovascular diseases, autoimmune diseases, and cancer. To this end, the researchers suggest that each of us should appropriately reduce the use of disposable plastics and avoid the use of plastic products in high temperatures.
Around this topic, some netizens pointed out that the reason for eating micro-plastic is not coffee, but plastic paper cups with hot drinks, so do not need to takeaway paper cups or plastic cups, with their own cup; there are also Buddhist netizens said that "workers are not so exquisite, casually".
We found microplastic in all of these places in our bodies
Plastic products have become essential things in people's production and life. However, the widespread use of plastic products also increases the risk of microplastics entering the body.
Microplastics are difficult to be absorbed by the human body, and the parts that fail to discharge will accumulate in the body, exceeding a certain amount may cause damage to organs and cells to varying degrees. Even more shocking, scientists have discovered the presence of microplastics in several organs of the human body.
1. The brain
In April 2023, published by an international scientific team in nanomaterials, a new study of mice showed that microplastic particles can cross the blood-brain barrier and enter the brain in just two hours after being photographed.
Some microplastic particles penetrate the gut and blood-brain barrier in a short time. Researchers say that plastic particles in the brain can increase the risk of inflammation, neurological disorders, and even neurodegenerative diseases such as Alzheimer's disease or Parkinson's disease.[2]
2. The heart
Professor Yang Xiubin and Hua Kun from Beijing Anzhen Hospital affiliated to Capital Medical University published a paper titled "Detection of Various Microplastics in Heart Surgery Patients" in the journal Environmental Science and Technology. The pilot study of people undergoing heart surgery revealed the presence of microplastics in many heart tissues.
Although the study examined a small number of samples, the team said the study provides preliminary evidence that various microplastics can accumulate and persist in the heart and its innermost tissue. The results of this study also suggest that invasive medical behavior is a microplastic exposure route, providing a route of microplastics in direct contact with the blood and internal tissues and organs of the body.
3. Blood
In 2022, a study published in the authoritative journal International Environment showed that microplastics were found in the blood of the experimenters. This also means that microplastics or organs already found throughout the body have a great health risk.[3]

4. The stomach
In 2018, the European Society for Gastroenterology first reported the detection of up to nine microplastics in human feces, between 50 and 500 microns in diameter. Microplastics can reach the human stomach and may affect the digestive system.[4]
5. Lung
In an article published in the 2022 Chinese School Health, Li Mingju et al., the air sampling results of the mannequin showed that a mildly active male could inhale nearly 300 microplastic particles per day. On pathological examination, cellulose and plastic microfibers were seen in lung cancer tissues and adjacent lung tissue specimens.[5]
6. Placental
A study published in 2020 in the journal International Environment showed that researchers tested placentas from six healthy pregnant women and detected "microplastic particles" [6] in four of the placentas. This suggests that microplastics can affect the human body through the placental barrier.

reference material
[1] Assessing the Release of Microplastics and Nanoplastics from Plastic Containers and Reusable Food Pouches: Implications for Human Health.Environmental Science & Technology, 2023; 57 (26): 9782 DOI: 10.1021/acs.est.3c01942
[2] Microand Nanoplastics Breach the Blood–Brain Barrier (BBB): Biomolecular Corona’s Role Revealed.Nanomaterials 2023, 13(8), 1404; DOI: https://doi.org/10.3390/nano13081404
[3] Heather A.Leslie, Martin J.M.van Velzen, Sicco H.Brandsma, Dick Vethaak, Juan J.Garcia-Vallejo, Marja H.Lamoree,Discovery and quantification of plastic particle pollution in human blood,Environment International,2022,107199,ISSN 0160-4120.
[4] EurekAlert, Microplastics discovered in human stools across the globe in 'first study of its kind'
[5] Li Mingju, Li Zhuo, Bai Yinglong, Jia Lihong, Sun Wei, Pan Guowei, Yan Lingjun, Yang Zuosen. Effect of microplastics on child health [J]. School Health in China, 2022,43 (2): 316-320. doi: 10.16835/j.cnki.1000-9817.2022.02.036
[6] Ragusa A, Svelato A,Santacroce C, et al.Plasticenta: First evidence of microplastics in human placenta[J].Environment International, 146. DOI: 10.1016/j.envint.2020.106274.
Packaging tribe